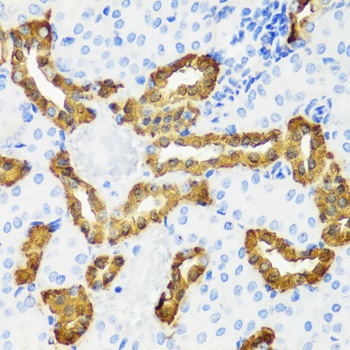
CALB1 Antibody

You have no items in your shopping cart.
Human
0.16-10 ng/mL
0.059 ng/mL
48 T, 96 TRat
0.16-10 ng/mL
0.061 ng/mL
48 T, 96 T- Calcitriol [orb1300876]
99.94%
32222-06-3
416.64
C27H44O3
50 mg, 100 mg, 200 mg, 2 mg, 5 mg, 10 mg, 25 mg - Vitamin D binding protein Antibody [orb395760]
ELISA, WB
Human
Mouse
Monoclonal
Unconjugated
100 μg, 50 μg